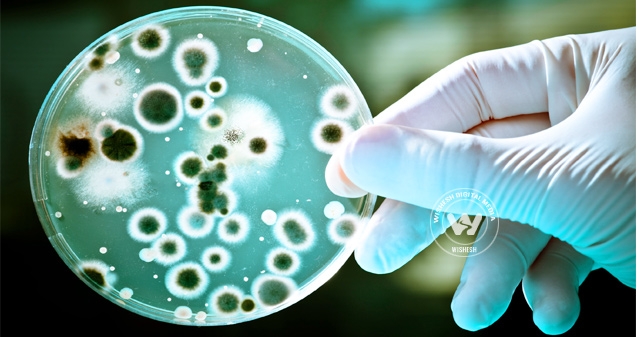
Death due to drug-resistant bacteria},{Death due to drug-resistant bacteria

(Image source from: Death due to drug-resistant bacteria})
The US government perhaps undertaking it's first ever initiative in it's approximation regarding the number of death due to drug-resistant bacteria every year. Beyond 23,000 otherwise as many as those destroyed annually by flu. The Centers for Disease Control and Prevention revealed the number during Monday to expose the exceedingly high threat of germs that are tough to treat are due to the reason that they've become resistant to drugs.
Expressed Dr Helen Boucher, a Tufts University expert and spokeswoman for the Infectious Diseases Society of America that finally approximating the problem sends a very powerful message and that they're facing a catastrophe.
Furthermore, antibiotics like penicillin and streptomycin first became widely available in the 1940s. At the same time today dozens are used to kill otherwise conquer the bacteria behind illnesses ranging from strep throat to the plague. In point of fact, the drugs are well thought out to be one of the greatest advances in the history of medicine as well as have safeguarded numberless lives.
(AW:SB)








